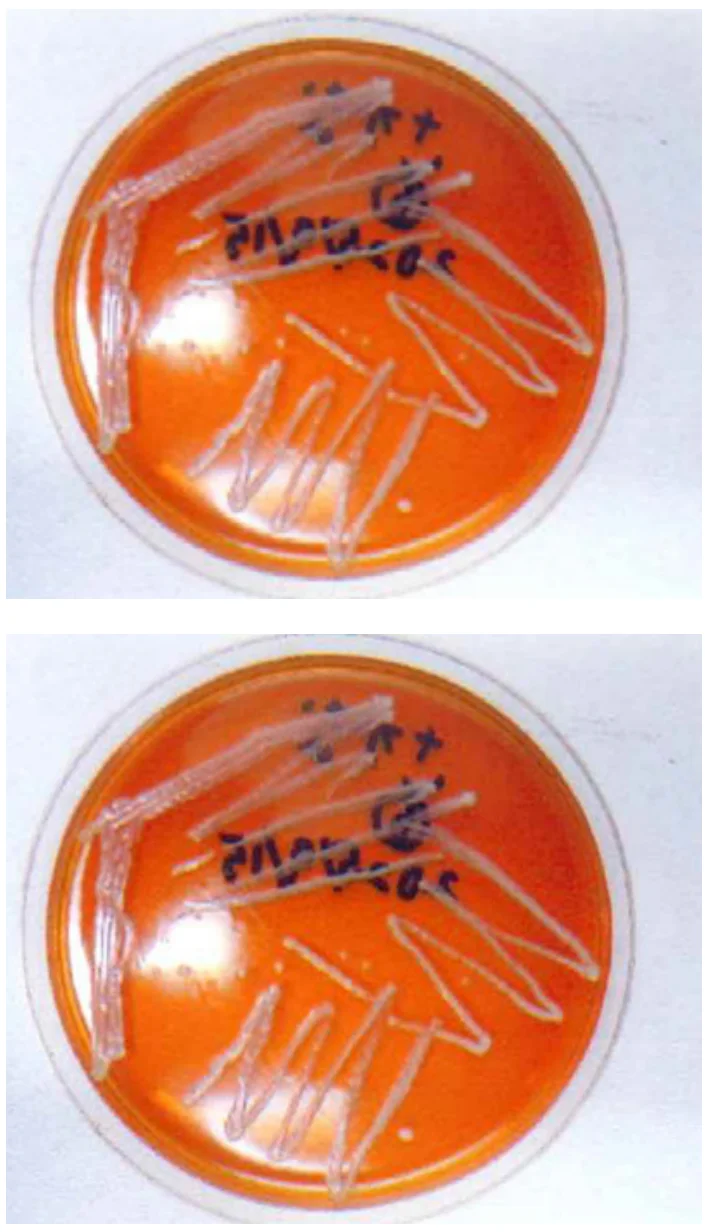

研究の背景
「はたらく細胞」というテレビアニメを観て、乳酸菌ががん細胞を攻撃するNK細胞を助けているのを知ったのが、この研究を始めるきっかけだ。
私が住む滋賀県には、「ふなずし」という伝統食がある。塩漬けのニゴロブナ(世界で琵琶湖にしか生息しない)とご飯(飯いいという)を漬けて発酵させたもので、昔から薬代わりに食べられる。ふなずしの飯には約200種類の乳酸菌が生きていて、私はこの乳酸菌に「しがきん」と名前をつけた。小学3年生の研究で、しがきんは生きて腸へ届き、腸内環境を整えることを知った。腸内のNK細胞が乳酸菌を捕まえて樹上細胞に渡すと、インターフェロンという細胞間で情報を伝える物質が作り出される。インターフェロンに反応して活性化したNK細胞が、がん細胞の中身を溶かすことも知った。1990〜2015年の統計を見ると滋賀県の平均寿命と健康寿命は日本一で、他の自治体と比べがんでの死亡率も低い。
小学4年生の研究では、しがきんのなかからNK細胞を活性化する特定の乳酸菌を発見することに挑戦した。そのためにまず国立国会図書館の既刊の乳酸菌図鑑を探したが、乳酸菌の一覧が載った文献は存在しなかった。そこで、しがきんの乳酸菌を同定(その乳酸菌の種や株を明らかにする)して、日本初の乳酸菌図鑑を自作することにした。同定した乳酸菌を図鑑に掲載していく作業は、大手食品メーカーや株式会社ヤサカ、琵琶湖博物館に協力をいただき、小学5年生でも続けた。
研究の目的
私には、しがきんでがんを治すという大きな夢がある。そのために図鑑だけでは、しがきんからNK活性を高める乳酸菌を発見することはできないと気がついた。乳酸菌の株まで調べる同定は、世界に80億人いる人(乳酸菌でいう属)から、1億数千万人の日本人(乳酸菌でいう種)を特定し、さらにそこから清水結香という名の個人(乳酸菌でいう株)を明らかにする作業だ。せっかく乳酸菌を同定することができても、株そのものを残しておかなければ、同じ株を再度探し出すのは不可能に近い。
小学6年生でも、乳酸菌の図鑑作りは続けていく。それに加えて、収集した株の長期保存を目指すことにした。また、これまでの研究で集めて放置していた乳酸菌の株を、もう一度培養して保存することにも挑戦してみる。
研究の方法
これまでの研究で実験に使っていたしがきんのサンプルは、小学3年生の時に私が手作りしたものだ。塩漬けのニゴロブナと飯をたるに敷きつめて、水を張って発酵させる昔ながらの手法で作った。このふなずしがなくなったため、新たなふなずしを作る必要があった。
昔ながらの手法は初夏から冬にかけて毎日、たるの水を入れ替えなければならない。滋賀県漁業協同組合連合会と龍谷大学の田邊公一先生の協力でもっと簡単に手作りする方法を知り、2025年春に食品圧縮袋で漬けるクラフトふなずし、夏に水の入れ替えが不要なたる漬けふなずしを作った。
①新しいサンプルで図鑑作りのためのしがきん培養実験を行い、②放置していた過去のしがきんの救出実験をした。さらに①と②で培養したしがきんを③同定するための実験をし、④それを保存する実験を行った。

水の入れ替えが不要なたる漬けふなずしを作る様子
実験①〜④
① しがきん培養実験
これまでの研究で収集に成功したしがきんは、ラクトバチルス属の乳酸菌だった。培養のための培地にはラクトバチルス属が増殖しやすいMRS寒天培地を使うことにし、シャーレに作った。サンプルには、クラフトふなずしとたる漬けふなずしそれぞれの、フナの腹中の飯と、フナにはふれていない外側の飯を使う。合わせて4種類のサンプルを生理的食塩水で10倍、100倍、1000倍、10000倍、100000倍に薄めて個別に培地へ植菌し、37℃に温めたインキュベーターで培養した。
24時間培養後、たる漬けふなずしのすべての培地にはコロニー(乳酸菌の塊)ができていて、特にフナ腹中のシャーレのほうで多くのコロニーが増え育っていた。クラフトふなずしのほうはすべてのシャーレでコロニーが確認できず、48時間培養した。するとようやく多くのシャーレにコロニーができたが、薄く希釈したシャーレはコロニーができないものもあった。これは、2カ月でできあがるクラフトふなずしを、乳酸菌が増えると考えて半年以上も発酵させたからだと思う。
同定実験に備え、シャーレに現れたコロニーのうちのひとつを別のMRS寒天培地に分離培養する。コロニー同士が密集する場所を避け、ポツンと現れたものを別の培地に塗り広げてインキュベーターで48時間培養し、冷蔵庫で保存した。
分離培養したクラフトふなずしのコロニー(上)とたる漬けふなずしのコロニー(下)
② しがきんの救出実験
今回救出するのは、小学4年生の時に分離培養した7株のしがきんのMRS寒天培地と、小学3年生の時に手作りしたふなずしの飯で、どちらもずっと冷蔵庫に放置していた。7株の培地からは新たな培地へ植菌してコロニーを復帰させる植えつぎを、飯からは新たな培養を試みる。これだけ長く放置していると救出は難しい作業で、龍谷大学の田邊先生に指導していただいた。
植えつぎではMRS培地のほか増殖が難しい細菌に使われる栄養価の高いBHI培地も使い、30度のインキュベーターで96時間培養した。しがきんのコロニーが復帰するまで、何回も試してみる。私が植えつぎをしたのは2回だったが、その後も田邊先生が複数回試みてくださり、冷蔵庫にあった7株のうち4株の培地から何かの細菌のコロニーが復帰した。飯の培養でも、大きく分けて3種類のコロニーが観察できた。
③〜④ しがきんの同定実験と保存
同定はまず、乳酸菌の特徴を備えているかを調べる。グラム染色法(染色することで細菌を2種類に分ける)が陽性(紫)であること、細胞の形が棒のような桿菌か、丸い球菌であること、カタラーゼ試験が陰性であること(過酸化水素を滴下した時に泡が発生しない)。次にラクトバチルス属と関連する乳酸菌を同定できるキット「アピ50CHL培地」と「アピ50CH」で、簡易同定を行った。最後にPCR法(DNAの特定領域を増幅させる)で増やした16S rRNA遺伝子の塩基配列をシーケンサーで解析し、インターネットサービス「BLAST」のデータベースでしがきんの種を同定した。
その結果、サンプルを採集した場所に関係なく、①のクラフトふなずしの細菌はすべて「ワイセラ ビリデセンス」、たる漬けふなずしはすべて「リモシラクトバチルス ファーメンタム」という異なる乳酸菌だった。②で培地から救出した細菌からは「ラクチカゼイバチルス パラカゼイ」という乳酸菌1種だけが確認できた。飯から培養したのもほとんどが魚由来の細菌で、「レンチラクトバチルス ヒルガルディ」という種の乳酸菌(菌株が違う2株分)が見つかった。今回、同定した乳酸菌の培地はすべて龍谷大学発酵醸造食品機能研究センターで液体培養し、ディープフリーザーに凍結保存した。
2025年の夏、小学3年生の時から変わらず研究に全面協力していただいた株式会社ヤサカの八坂正博会長が亡くなった。大切な人が天国へ行ってしまうのは、とても悲しい。身近な人を亡くした世界中の人もきっと、同じ気持ちだと思う。がんで天国へ行く人が世界からいなくなるために、これからもしがきんの研究を続けていきたい。

飯から見つかったレンチラクトバチルスヒルガルディ種2株の簡易同定の判定結果、同じ種でも反応が全く違った
[審査員] 飯田 秀男
小学校3年生から、NK細胞の活性化に寄与することをねらいとして、自然免疫である乳酸菌に関する研究を継続して行った実践です。4年生から「しがきん」に焦点を当て、「しがきん」図鑑を策定するために、5年生まで継続して取り組み7種の株を同定することができました。今年は、ふなずしを作って研究をさらに進めました。さまざまな方法を駆使しながら、菌を同定することができました。さらに、見つけた乳酸菌を活用するために長期保存に取り組み、成果を残しました。民間の会社の方や大手の企業などの研究所の研究員や大学の先生からのアドバイスや協力を得ながら、自分のものとして継続して研究されたことは素晴らしいことです。がんで亡くなる人を減らしたいという思いと、身近にある「ふなずし」を関係付けた素晴らしい研究となりました。今後も乳酸菌をはじめとした食と健康の関係を追究し続けることで、研究のきっかけとなった「がんをなくす」という願いをかなえてほしいと思います。


龍谷大学農学部食品栄養学科 教授 応用微生物学研究室 田邊 公一
結香さんから乳酸菌の冷凍保存について相談を受けた際、滋賀県の発酵食品であるふなずしの研究を通して、将来的にがん治療に生かしたいという純粋で真摯な想いをうかがいました。地元に根付いた伝統食品の長所を科学的に捉え、医療分野へと結びつけようとする発想は大変素晴らしいと感じました。また、結香さん自身が研究計画を具体的に立て、実験内容の説明を正しく理解したうえで的確な質問をされていた点にも驚かされました。実験操作や結果の整理、考察に至るまで丁寧に取り組み、妥協せず目標を達成しようとする姿勢には強い感銘を受けました。すでに研究者の仲間入りを果たしている結香さんですが、中学・高校・大学と学びを深める中で、さらに新しい研究テーマに出合うことでしょう。今回の経験を糧に、今後も興味を持った分野(微生物研究であったらうれしいですが)で存分に活躍してくれることを期待しています。